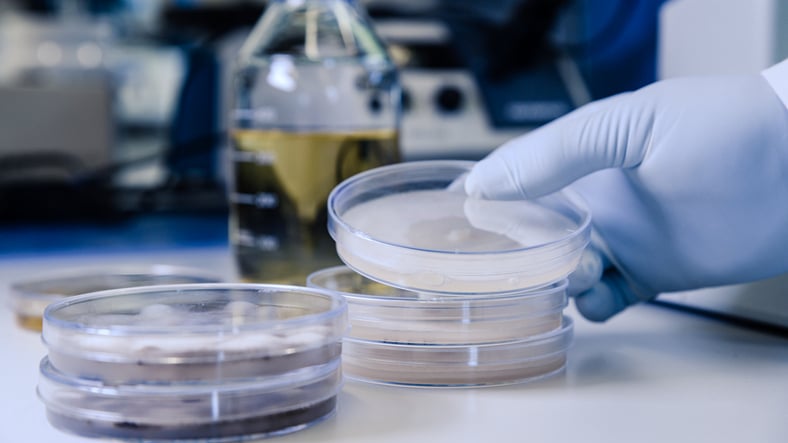

Single-Vent vs. Triple-Vent Microbiology Media Plates: What’s the Difference?
Written By: Leonor Araújo |
This article explores how single-vent and triple-vent microbiology media plates differ, and how those differences affect real-world laboratory work. Topics we'll cover include:
- How plate venting influences gas exchange, condensation, and evaporation
- Why single-vent and triple-vent designs behave differently during incubation
- Which venting format is better suited to short-term vs. long-term cultures
- How airflow impacts agar stability and colony morphology
- What practical factors to consider when selecting plates for routine QC work
- How to choose the correct format to support different workflows, and why many labs carry both
Why does venting in prepared microbiology media plates matter?
When choosing prepared microbiology media plates, there are several factors to consider. Choice isn’t based only on agar formulation, it also depends on how the plate design supports airflow, moisture balance, and microbial growth. An important issue is lid venting, which plays a significant role in how the internal environment of the plate is maintained.
Vented Petri dishes incorporate small protrusions or spacing features on the inside of the lid. These prevent the lid from forming a complete seal against the base, allowing controlled gas exchange between the internal plate environment and the surrounding air.
This airflow is essential for aerobic microorganisms that rely on oxygen availability for growth. Venting also helps manage condensation within the plate, which can otherwise obscure colonies, interfere with streaking patterns, or lead to uneven growth across the agar surface.
How does venting influence evaporation and what does that mean in practice?
While venting supports gas exchange and helps control condensation, it also determines how quickly moisture is lost from the agar surface during incubation. Evaporation directly affects agar dryness, colony morphology, and overall culture viability.
Increased airflow accelerates agar moisture loss, which can be beneficial in the short term: reduced condensation produces clearer, more uniform culture surfaces, supporting accurate colony counting, streaking, and rapid screening workflows.
However, evaporation must be carefully balanced. Excessive moisture loss can lead to agar shrinkage, cracking, or desiccation, potentially compromising environmental monitoring results—particularly during longer incubations.
This balance between airflow and moisture retention is where single-vent and triple-vent plate designs differ most clearly in practice:
- Single-vent plates allow limited airflow by lifting the lid at a single point. This restricts evaporation while still supporting aerobic growth, helping retain moisture over time. As a result, single-vent plates are better suited to longer incubations, where maintaining agar integrity is critical. They are commonly used for extended aerobic cultures, antibiotic susceptibility testing, and work involving slow-growing bacterial or fungal species.
- Triple-vent plates have multiple vents spaced around the circumference of the lid, to promote greater and more uniform airflow. This enhances gas exchange and accelerates moisture dissipation, reducing condensation and surface moisture during short-term incubation. For this reason, triple-vent plates are well suited to applications where clarity is essential and incubation times are limited, such as colony isolation, rapid assays, and teaching laboratories. In longer incubations, however, the same increased airflow can raise the risk of dehydration, making triple-vent designs less appropriate where moisture retention is required.
- Incubation duration: longer studies benefit from moisture retention
- Oxygen demand: highly aerobic organisms favor increased airflow
- Condensation sensitivity: triple-vent plates offer clearer surfaces
- Environmental humidity: dry conditions may accelerate dehydration
- Laboratory airflow: reduced venting can offer added protection
For reference, non-vented plates are typically used for anaerobic applications, where exclusion of oxygen is required.
Understanding how venting influences evaporation allows laboratories to select plate designs that align with incubation time, organism growth characteristics, and environmental conditions, ensuring reliable, reproducible results.
Quick Reference: Single-vent vs. Triple-vent Prepared Media Plates
|
Feature |
Single-vent Plates |
Triple-vent Plates |
|
Gas exchange |
Limited, controlled |
High, continuous |
|
Evaporation rate |
Low—retains moisture |
High—dries faster |
|
Condensation control |
Moderate |
Excellent |
|
Best suited to |
Long-term incubations |
Short-term assays |
|
Agar stability |
High |
Lower over extended time |
|
Typical applications |
Antibiotic testing, slow growers |
Streaking, rapid cultures |
Source: AnalytiChem
Single-vent vs triple-vent: how to choose the right prepared media plate
Single-vent and triple-vent prepared media plates serve different, equally important roles in microbiology laboratories. Many labs hold both formats, allowing teams to match plate design to experimental goals rather than forcing a single compromise.
The right choice depends on how airflow, evaporation, and incubation time interact with the organisms being studied. When selecting between single-vent and triple-vent plates, it’s important to consider several factors:
By understanding how venting influences culture behavior, laboratories can make more informed decisions—improving data quality, reducing repeat work, and ensuring prepared microbiology media perform as intended.
For more information about the availability of Redipor prepared microbiology media, including single- and triple-vent plates in your region, or to request a quote, contact our team, we’re here to help.
Leonor Araújo is AnalytiChem’s Global Product Manager, Traded Products, Life Sciences.



